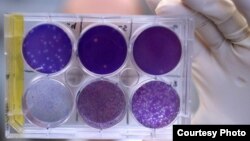
Nhà nghiên cứu cầm một chiếc khay có virus Zika đang phát triển trong những tế bào động vật ở Trường Y khoa thuộc Đại học Washington, St. Louis, Missouri.

Đã có một bước đột phá trong công cuộc tìm kiếm một phương cách chữa trị virus Zika. Những nhà nghiên cứu đã phát hiện một loại kháng thể làm giảm đáng kể mức độ nhiễm Zika, và có tiềm năng được bào chế thành một loại vắc-xin để bảo vệ phụ nữ mang thai khỏi loại virus do muỗi truyền này.
Nó được gọi là ZIKV-117, một loại protein của kháng thể hoặc của hệ miễn dịch mà những nhà nghiên cứu đã cô lập từ một bệnh nhân bị nhiễm virus Zika.
Trong một nghiên cứu bao gồm những con chuột mang thai bị nhiễm mầm bệnh do muỗi truyền này, ZIKV-117 đã bảo vệ bào thai khỏi bị nhiễm trùng. Kháng thể này, kích thích một phản ứng mạnh mẽ của hệ miễn dịch chống lại virus, vô hiệu hóa tất cả các chủng Zika được thử nghiệm. Số lượng virus ở chuột mẹ được hạ thấp đáng kể, số lượng mầm bệnh được tìm thấy trong mô bào thai, mô nhau thai và mô não cũng giảm.
Chuột đực nhiễm bệnh được cho một liều ZIKV-117 duy nhất có tỉ lệ sống sót hơn so với chuột không được chữa trị, thậm chí năm ngày sau khi nhiễm Zika. Điều này cho thấy kháng thể này có thể được sử dụng để chữa trị tình trạng nhiễm trùng đang hoạt động.
Khám phá này được thực hiện bởi những nhà nghiên cứu tại Trường Y thuộc Đại học Washington ở bang Missouri và Đại học Vanderbilt ở bang Tennessee của Mỹ, và được đăng tải trên chuyên san Nature.
Đây là lần đầu tiên các nhà nghiên cứu tìm ra phương cách chữa trị Zika, theo lời Michael Diamond, một nhà vi sinh học và miễn dịch học tại Đại học Washington và là đồng tác giả chính của nghiên cứu này. "Trước nghiên cứu này, không có vắc-xin nào hay bất kỳ nghiên cứu nào khác thử nghiệm bất cứ thứ gì ở động vật mang thai để cho thấy rằng có thứ gì có thể tiêu trừ hoặc ngăn ngừa căn bệnh. Vì vậy, một điều mà nghiên cứu này làm được là cho thấy các kháng thể có thể làm điều đó và điều này thực sự là tín hiệu tốt cho những nỗ lực bào chế vắc-xin trong tương lai," ông nói.
Zika có thể gây ra dị tật bẩm sinh nghiêm trọng, đặc biệt là chứng đầu nhỏ ở trẻ sơ sinh của những người phụ nữ bị nhiễm virus trong khi mang thai. Trẻ sơ sinh bị dị tật đầu nhỏ có có đầu và não nhỏ bất thường.
Zika cũng được cho là gây nên một tình trạng tê liệt thần kinh hiếm gặp ở người lớn được gọi là hội chứng Guillain-Barré.
Ông Diamond cho biết các nhà nghiên cứu giờ đang chuẩn bị thử nghiệm kháng thể này ở khỉ, một quá trình mà ông nói có thể mất từ sáu đến chín tháng. Nếu những thử nghiệm này thành công thì thử nghiệm trên con người có thể bắt đầu ngay sau đó.